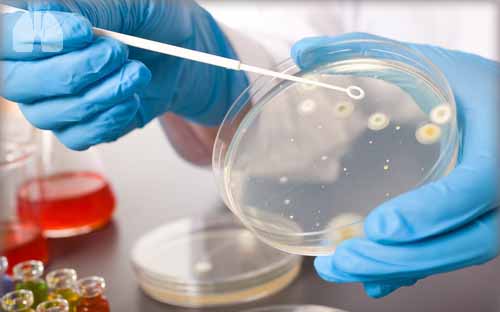

Abstract
Introduction: Ciprofloxacin dry powder for inhalation (DPI) is a formulation (PulmoSphere™ technology) in development for long-term therapy of non-cystic fibrosis bronchiectasis (non-CF BE). This phase II, randomized, double-blind study was designed to assess efficacy and safety over 28 days in non-CF BE patients with positive sputum culture for predefined respiratory pathogens (RPs).
Methods: Adult patients with non-CF BE received 32.5 mg ciprofloxacin (50 mg ciprofloxacin DPI) or matching placebo bid for 28 days, with a 56-day follow-up. The primary endpoint was reduction in total bacterial load in sputum at end of treatment (EOT). In addition, eradication of RPs and reduction of individual species was documented.
Results: The primary endpoint of significant reduction in bacterial load of RPs at EOT was achieved (log10 –3.6 vs –0.3 for placebo, p<0.001). In addition, greater reductions and eradications were achieved for the major pathogenic species including, Pseudomonas aeruginosa, Haemophilus influenzae, Moraxella catarrhalis and Streptococcus pneumoniae. The eradication rates for the baseline pathogens at EOT were 35% vs 8% for placebo. At EOT, eradication was achieved in all patients infected at baseline with M. Catarrhalis and in all but 1 patient infected with H. influenzae.
Conclusions: Ciprofloxacin DPI achieved a significantly greater reduction in total bacterial burden than placebo. A promising trend in reduction and eradication of the major pathogenic species was also noted. Ciprofloxacin DPI has demonstrated promise for long-term inhalation therapy to reduce the major pathogenic species in non-CF BE, which could reduce the incidence of exacerbations.














